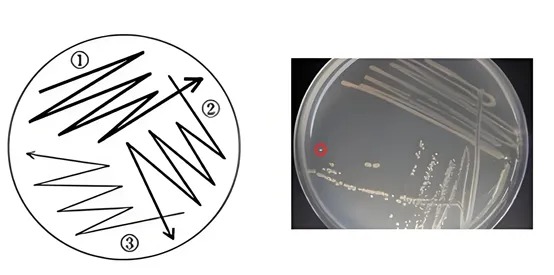

對于在-80℃保存時間較久的甘油菌,有可能出現以下情況:(1)被雜菌污染;(2)目的菌質粒丟失;(3)目的菌活性變低。所以,需要通過平板劃線、篩選培養,重新獲得高活性的單個目的菌。
二、如何進行平板劃線?
1、三區平板劃線
將平板劃分為三個逐漸縮小的區域,接種環依次密集到稀疏劃線,并與前一區輕微搭接,通過逐級稀釋在第三區獲得單菌落,常用于臨床標本的首次分離,尤其適合菌量不高的樣品。
2、四區平板劃線
在三區基礎上增加一個區域,四個區域依次遞減、輕微搭接,稀釋效果更徹底,能進一步降低菌量密度,適合污染嚴重或菌量高的樣品,提高純培養的成功率。

3、單次連續之字劃線
接種環從平板一端到另一端連續劃“之”字,不交叉、不重復,使菌液沿全程均勻分布,適合菌量已知的純培養或增菌液接種;也可用于混合樣本分離,但稀釋梯度不如分區劃線明顯,獲得單菌落的概率相對較低。
4、網狀平板劃線
先做一次“之”字劃線,再將平板旋轉90°進行垂直劃線,形成交叉網格,增加劃線面積和稀釋機會,適合生長緩慢或菌落細小的微生物分離,但交叉處菌落可能過密。
三、三區平板劃線操作步驟
1、 左手拿培養皿,右手持接種環,打開蓋子一條縫隙,將沾菌接種環在平皿邊緣“之”字劃第一區域(約 1/4~1/5 面積)。
2、 轉動培養皿約 120°,灼燒冷卻接種環,從第一區末端帶菌在第二區劃線。
3、 再轉動培養皿約 120°,灼燒冷卻接種環,從第二區末端帶菌在第三區劃線。
?? 注意:各區劃線僅與前一區少量相交,絕不與其他區域重疊;全程應在超凈工作臺中進行。
四、常見問題及解決辦法
1、菌落連成一片(“草坪”)
原因:菌量過大或劃線過密,稀釋梯度不足。
解決:甘油菌先 10??~10?? 稀釋;第二、三區再稀疏些;必要時改用四區法。
2、平板無菌落
原因:菌已失活或接種量過少;抗性平板選錯抗生素;培養條件不符。
解決:換用新鮮甘油菌、降低抗生素濃度、檢查培養溫度/氣體條件。
3、雜菌覆蓋目的菌
原因:甘油菌污染或操作污染。
解決:重新劃線時加入目的菌特需抗性/顯色底物;操作前用75%酒精擦拭工作臺并紫外再照15 min;必要時用無菌濾紙貼蓋法二次純化。
4、 單菌落過少或分布不均
原因:接種環未充分冷卻殺死部分菌;旋轉角度不足導致稀釋梯度不足。
解決:灼燒后冷卻 5–10 s;確保每區旋轉≈120°;可在第三區尾端再輕劃兩條補充線。






